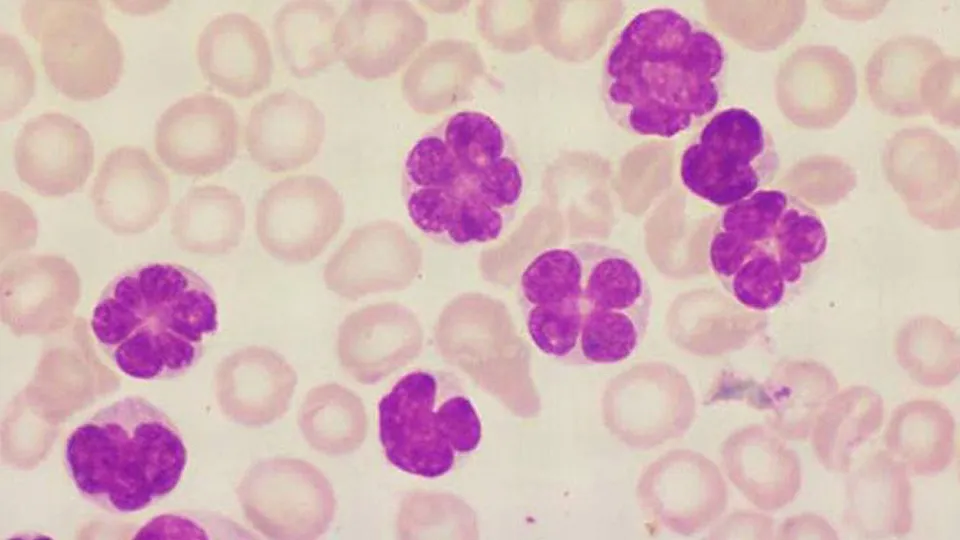

The Department of Cell Biology at Albert Einstein College of Medicine engages in pioneering basic and translational research and provides exceptional graduate and postdoctoral training in cellular and molecular biology. We have a rich and distinguished history of scientific discovery and innovation, consistently ranking among the top 10 in the nation in funding from the National Institutes of Health and in the top 5 in NIH funding per investigator. Our outstanding faculty, many of whom hold cross-appointments in other clinical and basic science departments, are rising stars and prominent leaders in their respective fields.
Related News
Events

In person
CB WIP
Friday, May 29 from 12:00pm - 01:00pm
Forchheimer Medical Science Building – 5th Floor Lecture Hall
Contact Us
Albert Einstein College of Medicine
1300 Morris Park Avenue
Chanin Building, Room 405
New York, NY 10461